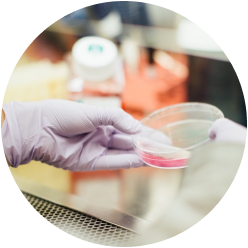

Since 1989
built with Trust
코인텍은 라벨, 스티커 산업에서 광고용, 건축, 차량용 필름에 이르기까지
30년 넘게 수많은 파트너의 요구에 맞는 제품을 생산해 왔습니다.
많은 파트너들이 오랜 기간 코인텍과 함께 한 이유는 원자재 수급부터
제품 판매 이후의 모든 가치 사슬 단계에서 고객 브랜드 가치를
최우선으로 생각하기 때문입니다.
코인텍은 더불어 성장한다는 이념을 바탕으로 신뢰로 성장합니다.
커스텀 솔루션 프로세스
❶ 고객 요구사항 확인
원단 특성 : 표면 코팅, 두께, 원단 층, 인쇄 패턴, 출력 잉크 등
점착 : 점착 강도, 사용 환경 및 용도, 유지력 등
이형지 : 이형지 종류(PET, 종이류), 두께, 표면 코팅 특징 (PE, 실리콘)
패키징 : 요구 폭, 길이 등 맞춤 재단, 박스 및 기타 패키징 방식
❷ 원자재 공급 조사 및 개발
❸ 개발 완료 샘플 시험 생산
❹ 샘플 품질 검사 실시
❺ 완제품 샘플 생산 완료 및 고객 확인
커스텀 솔루션 주요제품
디지털 프린팅 미디어
스크린 인쇄 필름
라미네이팅 필름
컬러 시트
샌드블라스트 테이프
창문용 필름
인테리어 필름
차량용 필름
향균 필름
반사 시트
디지털 프린팅 미디어
스크린 인쇄 필름
라미네이팅 필름
컬러 시트
샌드블라스트 테이프
창문용 필름
인테리어 필름
차량용 필름
향균 필름
반사 시트
품질 관리 및 검사
고객사와 최종 소비자에게 안정적으로 제품을 공급하고 제품 신뢰도 제고를 위해 코인텍은 ISO 9001, ISO14001 에 따른 철저한 품질 관리 및 환경 경영 시스템을 운영합니다. 모든 생산 공정에서 점착, 코팅, 원자재 검사를 실시하며, 품질/개발 연구 시설을 운영합니다.

원단 코팅, 색상, 평활도 검사

점착제 도포량 측정

인장력 테스트
난연 시험

45도 연소 시험

컷팅 플로터 테스트

항온, 항습 지속력 테스트

유지력 테스트
